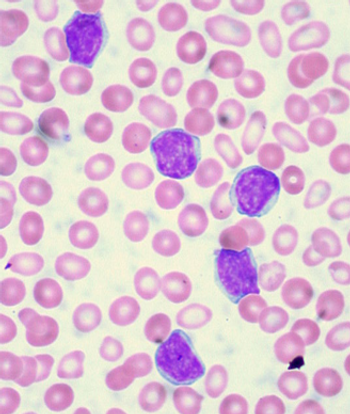

Using both clinical and molecular markers, researchers have created a simple prognostic index for patients with cytogenetically normal acute myeloid leukemia (AML).

Your AI-Trained Oncology Knowledge Connection!


Using both clinical and molecular markers, researchers have created a simple prognostic index for patients with cytogenetically normal acute myeloid leukemia (AML).

New trial results show that a novel, oral metabolic inhibitor has demonstrated early activity in relapsed or refractory acute myeloid leukemia (AML), according to data presented at the annual meeting of the American Association of Cancer Research.

A subgroup of chronic myeloid leukemia (CML) cells that were “sticky,” or adherent to plastic, showed higher expression levels of BCR-ABL and were more resistant to treatment with the tyrosine kinase inhibitor imatinib.

A phase II trial of mogamulizumab showed that the agent has meaningful antitumor activity in patients with relapsed peripheral T-cell lymphoma and cutaneous T-cell lymphoma, and acceptable toxicity.

MolecularMD and Novartis are working on a diagnostic test to help determine which chronic myeloid leukemia patients may be candidates to stop taking nilotinib.

Although the cure rate remains high in women who present with bulky mediastinal stage I–II HL, the challenge remains to balance efficacy and minimize long-term toxicities.

Contrary to some previous research as well as popular belief, living underneath or near to power lines as a child may not have any notable effect on childhood leukemia risk, according to a new case-control study conducted in the United Kingdom.

Researchers have identified distinct pre-leukemic hematopoietic stem cells (HSCs) in acute myeloid leukemia (AML) patients.

A score based on an epigenetic signature of hematopoietic stem cells (HSCs) is highly prognostic for patients with acute myeloid leukemia (AML), according to a new study.

The FDA has approved ibrutinib (Imbruvica) as a single-agent treatment for previously treated patients with chronic lymphocytic leukemia (CLL), under the FDA’s accelerated approval program.

The combination of idelalisib with rituximab improved survival in relapsed CLL, and idelalisib also showed antitumor activity as a single agent in patients with indolent non-Hodgkin lymphoma.

Activating mutations in the beta-catenin gene in bone cells is shown to contribute to the development of acute myeloid leukemia.

After significant improvement in progression-free survival with ibrutinib over ofatumumab, an independent data monitoring board has recommended stopping a phase III trial involving patients with relapsed or refractory CLL or SLL.
In a new study, combining the anti-CD20 antibody obinutuzumab with chlorambucil improved outcomes over rituximab and the same agent in chronic lymphocytic leukemia patients with coexisting conditions.

No definite guidelines exist for the management of nongastric MALT lymphoma. Retrospective series have included patients treated with different modalities, and excellent cause-specific and overall survival have been demonstrated, independent of the type of treatment adopted.

Chronic myeloid leukemia (CML) patients with higher copayments for the tyrosine kinase inhibitor imatinib were more likely to discontinue the drug or be non-adherent, according to a new study.

A deep molecular response to imatinib, achieved by most chronic myeloid leukemia patients who receive the drug, is predictive of better overall survival, according to a new study.

Modulation of the bone marrow microenvironment with parathyroid hormone may be a feasible way to dramatically reduce counts of leukemia stem cells in chronic myeloid leukemia patients, according to new research in mice.

Mesotheliomas that arise after patients receive radiation therapy for lymphoma have unusual histologic features, and those patients tend to be younger and tend to survive longer than more common asbestos-related mesothelioma patients.

A new phase II trial found that a regimen containing rituximab, gemcitabine, cyclophosphamide, vincristine, and prednisolone is active and reasonably safe in patients with diffuse large B-cell lymphoma and coexisting cardiac disease.

A study aimed at defining the natural history of breast implant-associated anaplastic large-cell lymphoma found that outcomes differ between those cases where the disease is confined within the fibrous capsule surrounding the implant and those where a mass is present in the breast.

Although the prospect is tempting, we do not believe there are sufficient grounds at this time to abandon bone marrow biopsy in patients with lymphoma. It still provides robust prognostic information, and in the majority of patients it remains an indispensable staging tool.

Clearly, eliminating a bone marrow biopsy in appropriate patients would be another step in the direction of minimizing the torture to which they are subjected.

A phase III trial of idelalisib plus rituximab in patients with previously treated chronic lymphocytic leukemia found that the combo improved progression-free and overall survival, according to results presented at the 2013 ASH meeting.

Treatment with gemtuzumab ozogamicin improved the event-free survival in children and adolescents with acute myeloid leukemia by reducing the risk of relapse among those able to achieve remission, according to trial results presented at the 2013 ASH meeting.